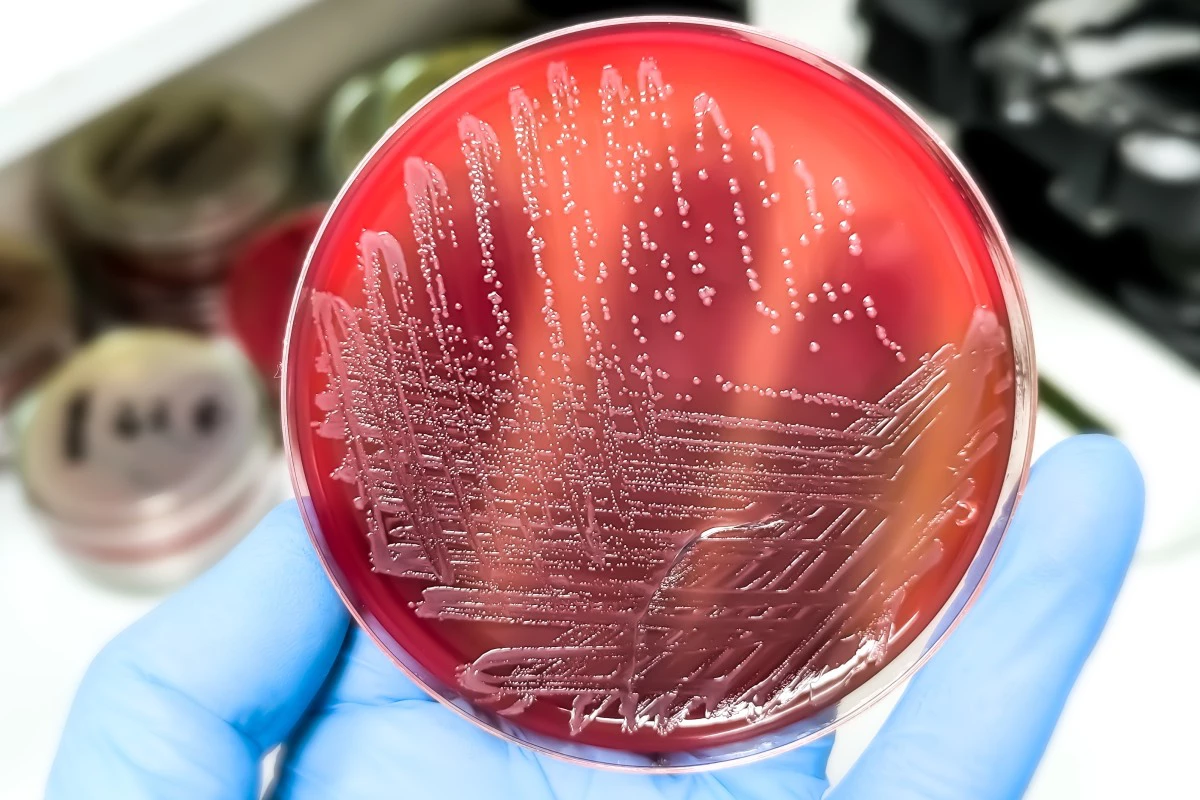
Определить наличие сальмонеллы на глаз невозможно, предупреждают эксперты

Что такое сальмонеллез и как от него защититься: советы врачей
. Риски, симптомы и простые меры защиты
Salmonella широко распространены в окружающей среде и отличаются высокой живучестью
Сальмонеллез остается одной из самых распространенных пищевых инфекций, однако врачи уверяют: достаточно соблюдать всего нескольких простых привычек при готовке, чтобы свести риск заражения к нулю. Вместе с экспертами разбираем, что это за инфекция и как защитить от нее себя и семью.
Материал прокомментировали:
- Александр Горелов, заместитель директора по научной работе ФБУН ЦНИИ эпидемиологии Роспотребнадзора, академик РАН;
- Юлия Юшина, руководитель лаборатории микробиологии, заместитель руководителя испытательного центра ФГБНУ «ФНЦ пищевых систем им. В.М. Горбатова».
Что такое сальмонеллез
Определить наличие сальмонеллы на глаз невозможно, предупреждают эксперты
Сальмонеллез — это острая кишечная инфекция (ОКИ), которую вызывают бактерии сальмонеллы (Salmonella). Существует много разновидностей этой бактерии, в настоящее время известно более 2,5 тыс. серотипов.
Salmonella широко распространены в окружающей среде и отличаются высокой живучестью. Они способны переносить засуху в течение нескольких недель, а в воде оставаться жизнеспособными на протяжении месяцев. Однако большинство из них не вызывают пищевого отравления.
В России и во многих других странах основным виновником вспышек болезней является один конкретный тип — Salmonella Enteritidis, который чаще всего связан с куриными яйцами и мясом птицы, свининой, говядиной, непастеризованным молоком. Эта группа микроорганизмов входит в число четырех ведущих причин диарейных заболеваний в мире. По статистике ВОЗ, ежегодно ими болеют около 550 млн человек, включая примерно 220 млн детей младше пяти лет.
Опасаться ли этой бактерии? Да, но без паники, считают врачи.
«Риск существует, но его можно почти полностью исключить, соблюдая простые правила, — пояснила Юлия Юшина. — Опасность в том, что для заражения иногда достаточно небольшого количества бактерий».
Как происходит заражение сальмонеллезом
Заражение сальмонеллой происходит через грязные руки, пищу или воду, объяснил Александр Горелов. Иными словами, бактерии попадают в организм человека только одним путем — через рот.
Так, можно съесть продукт, в котором бактерии успели размножиться из-за неправильного хранения или приготовления. Чаще всего это касается сырых или плохо приготовленных птицы, яиц, мяса и блюд на их основе. Реже инфекция передается через грязные руки, например после контакта с сырым мясом, если случайно после этого коснуться рта.
Определить наличие сальмонеллы на глаз невозможно, предупреждают эксперты. Зараженные продукты выглядят и пахнут совершенно нормально. Если бактерия все-таки оказалась в пище, это означает, что на каком-то этапе — при производстве (на ферме), переработке, транспортировке или хранении в магазине — произошел сбой в санитарном контроле. Но даже в такой ситуации опасности можно легко избежать, если следовать простым правилам на кухне.
Симптомы сальмонеллеза
Заражение сальмонеллой происходит через грязные руки, пищу или воду
Инкубационный период сальмонеллеза — от шести часов до двух-трех суток. Заболевание сопровождается обычными для пищевого расстройства симптомами.
«Для точной диагностики необходимы лабораторные исследования, — рассказал Александр Горелов. — В ЦНИИ эпидемиологии Роспотребнадзора разработаны диагностические тесты методом ПЦР в формате мультипрайм, которые позволяют максимально эффективно расшифровать этиологическую причину заболевания, а также экспресс-тест на сальмонеллез».
Кроме того, рекомендуется провести бактериологические исследования, а на второй неделе заболевания — серологическую диагностику.
Лечение
Обычно сальмонеллез протекает относительно легко и проходит без специфического лечения. Однако у маленьких детей, пожилых людей и пациентов с ослабленным здоровьем потеря жидкости иногда может быть значительной, и это делает заболевание опасным из-за риска тяжелого обезвоживания [4].
По словам врачей, при симптомах ОКИ заболевшего необходимо немедленно изолировать от других. Инфицированный сальмонеллезом человек выделяет возбудителя и, следовательно, является источником заражения. У больного должны быть отдельные полотенце и посуда, чтобы минимизировать контакты, особенно с детьми.
При первых симптомах нужно обязательно обратиться к врачу. До прихода доктора рекомендуется постоянное питье — это может быть теплый чай или простая кипяченая вода небольшими порциями, чтобы не провоцировать рвоту, отметил специалист.
Для восполнения солей и жидкости применяют глюкозо-солевые растворы, однако их обязательно следует чередовать с обычной водой, а правильную дозировку рассчитает врач. Минеральную воду без назначения врача применять не рекомендуется, подчеркнул Александр Горелов.
Профилактика сальмонеллеза
После работы с сырым мясом или яйцами обязательно мойте руки, чтобы не перенести микробы на другие продукты
Главные правила по предотвращению заражения сальмонеллезом — не дать бактерии попасть в пищу и размножиться. Юлия Юшина назвала простые и эффективные способы, которые помогут уберечь себя и своих близких от заражения.
- Хранить сырую птицу и мясо стоит в плотно закрытой емкости на нижней полке, чтобы случайный сок не попадал на другие продукты.
- Мясо безопаснее размораживать в холодильнике — так исключается его длительное пребывание при комнатной температуре.
- Курицу не нужно ополаскивать под сильной струей воды — брызги могут разнести бактерии по кухне.
- Для сырой продукции и уже приготовленных блюд лучше использовать разные доски и ножи.
- Все поверхности и предметы, которые соприкасались с сырой продукцией, важно сразу вымыть с моющим средством.
- После работы с сырым мясом или яйцами обязательно мойте руки, чтобы не перенести микробы на другие продукты.
- Самый надежный способ обезвредить сальмонеллу — довести блюдо до полной готовности.
- Фрукты и овощи перед приготовлением необходимо тщательно промывать, а при использовании в сыром виде по возможности очищать от кожуры.
- Во время поездок лучше избегать сырого молока и продуктов из него, выбирая только пастеризованное или предварительно кипяченое.
- Лед также может быть источником риска, если он приготовлен из зараженной воды. Лучше вовсе отказаться от напитков со льдом, если вы не дома и не уверены в качестве воды.
- Мойте руки перед едой. Гигиена рук играет ключевую роль: их нужно мыть с мылом как можно чаще, особенно после контактов с животными и после посещения туалета.
Главное
- Сальмонеллез — это острая кишечная инфекция.
- Заражение происходит через рот: сальмонелла попадает в организм с плохо приготовленным или неправильно хранившимся продуктом, реже — через грязные руки.
- Точный диагноз подтверждают лабораторными исследованиями.
- Основная опасность сальмонеллеза связана с обезвоживанием и возможными осложнениями со стороны внутренних органов.
- Наибольший риск тяжелого течения — у маленьких детей, пожилых людей и пациентов с ослабленным иммунитетом.
- Полноценная термическая обработка надежно уничтожает сальмонеллу, поэтому хорошо прожаренное или проваренное мясо и яйца безопасны, а при соблюдении базовых правил гигиены риск заражения минимален.
- Во время путешествий следует избегать сырого молока и продуктов на его основе, а напитки и лед употреблять только из безопасной воды, в идеале — покупать бутилированную воду.